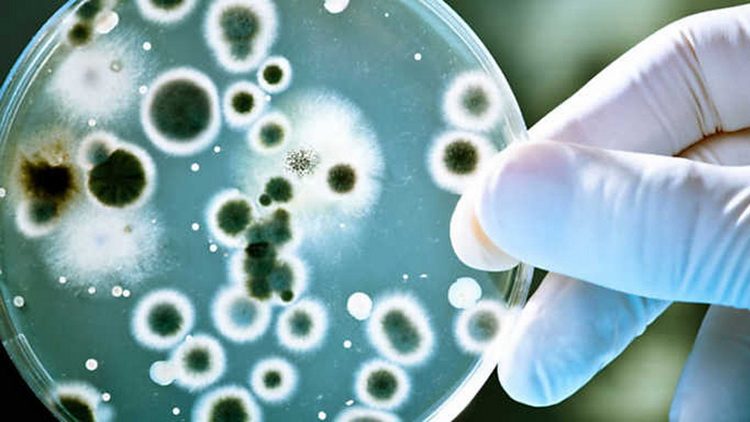

OTPORNOST NA ANTIBIOTIKE
Šta je Superbakterija i kako je nastala. Zašto je bakterija postala otporna na antibiotike i kakve to posledice ima
Rezistencija mikroorganizama na antimikrobne lekove je jedna od najvećih pretnji ljudskom zdravlju. Danas ona predstavlja vrlo raširenu pojavu, a neki su patogeni bakterijski uzročnici postali rezistentni na više različitih klasa antibiotika. Takve bakterije kolokvijalno nazivamo superbakterija.
Superbakterija zasejana na kulturi da bi se našao lek protiv nje
Danas brojne bakterije u svom genomu sadrže veći broj gena za rezistenciju te su otporne na više različitih klasa antibiotika.
Otkriće antibiotika i mogućnost lečenja po život opasnih zaraznih bolesti donelo je pravu revoluciju u medicini, no njihova laka dostupnost, propisivanje bez adekvatne indikacije i obilato korišćenje u poljoprivredi izazvalo je pojavu i širenje rezistentnih bakterijskih vrsta. Danas brojne bakterije u svom genomu sadrže veći broj gena za rezistenciju te su otporne na više različitih klasa antibiotika. Takođe, određeni bi uzročnici u ne tako dalekoj budućnosti mogli postati rezistentni na sve dostupne antimikrobne lekove, zbog čega brojni stručnjaci upozoravaju kako se približavamo tzv. postantibiotskoj eri. Upravo je zato važno neke od tih „superbakterija“ pobliže upoznati.
MRSA – meticilin-rezistentni Staphilococcus aureus
MRSA se uglavnom prenosi preko ruku zdravstvenog osoblja koje je bilo u kontaktu sa asimptomatskim kliconose ili inficiranim bolesnikom.
Meticilin-rezistentni Staphilococcus aureus (MRSA) predstavlja varijantu zlatnog stafilokoka sa izraženim genima rezistencije što mu omogućava otpornost prema beta-laktamski antibioticima i cefalosporinima, a neretko i drugim klasama antibiotika. Sposoban je da izazove čitav niz različitih bolesti – od infekcija kože i rana, pa do upale pluća i sepse sa smrtnim ishodom. Radi se o jednoj od najčešćih uzroka bolničkih infekcija, premda se u proteklih desetak godina ova bakterija rapidno proširila i u opštoj populaciji (dakle među ljudima koji prethodno nisu boravili u bolnici).
MRSA se uglavnom prenosi preko ruku zdravstvenog osoblja koje je bilo u kontaktu sa asimptomatskim kliconose ili inficiranim bolesnikom, što je često udruženo sa neadekvatnim pranjem ruku. Izvan bolnice se MRSA najčešće prenosi u situacijama bliskog kontakta većeg broja ljudi, kao što su sportski klubovi ili škole. Takav način prenosa dodatno pospešuju bliski kontakti kože na kožu, oštećenja kože u vidu posekotina, zagađene površine i nizak životni standard usled prenaseljenosti. Svakako je važno razlikovati kolonizaciju od infekcije meticilin-rezistentnim stafilokokom. Kolonizacija je stanje kada je bakterija prisutna bez kliničkih znakova bolesti, što nazivamo kliconoštvo. S druge strane, infekcija se događa kad bakterija uđe u tkivo i počne se umnožavati te se razvijaju simptomi bolesti.
Dijagnoza se postavlja kultivacijom odgovarajućeg materijala na hranljive podloge u mikrobiološkom laboratoriju. Razvijeni su i novi testovi koji omogućavaju detekciju genetskog materijala bakterije i njenih gena rezistencije s ciljem ubrzavanja čitavog dijagnostičkog procesa. Terapija se određuje prema antibiogramu, a u određenim slučajevima (poput razvoja apscesa) potreban je i hirurški zahvat ili drenaža. Treba naglasiti kako MRSA nije smrtonosnija od infekcije osetljivim sojevima zlatnog stafilokoka, već je opasnija zbog ograničenog arsenala antibiotika koji nam stoji na raspolaganju u njenom lečenju.
CRE – Enterobakterije rezistentne na karbapeneme
Zbog suženog izbora antibiotika kod infekcije rezistenznim Enterobakterije, u terapiji nam preostaju samo lekovi sa brojnim neželjenim dejstvima
Vrlo opasne i teško lječive infekcije Enterobakterije rezistentnim na karbapeneme (CRE) su u porastu među hospitalizovani pacijentima. Enterobakterije predstavljaju veliku porodicu bakterija sa dobro poznatim članovima kao što su Escherichia coli i Klebsiella pneumoniae, a karbapeneme su beta-laktamski antibiotici širokog spektra delovanja i neretko poslednja linija odbrane kod višestruko rezistentnih bakterija. Upravo su zbog toga CRE rezistentne na praktično sve antibiotike u kliničkoj praksi pa shodno tome ne čudi visoka smrtnost pacijenata kod kojih su ove bakterije prisutne u krvi.

BioImunitet kapi za imunitet i jačanje je rešenje za sve one kojima antibiotici ne deluju – klikni na sliku i naruči
Premda su, gledamo li Evropi u celini, takvi rezistentni sojevi retkost, u poslednjih nekoliko godina na području Balkana (a napose u Grčkoj) zabeležen njihov porast. Jedan od enzima koji je raširen u Hrvatskoj i koji Enterobakterije omogućava navedeno svojstvo rezistencije poznat je po skraćenici NDM-1 (prema eng. Nev Delhi metallo-beta-lactamase-1). Molekularna tipizacija gena za takve enzime pomoću elektroforeze u pulsnom polju važan je alat za praćenje i suzbijanje epidemije ovim uzročnicima. Zbog suženog izbora antibiotika kod infekcije rezistenznim Enterobakterije, u terapiji nam preostaju samo lekovi sa brojnim neželjenim dejstvima i sa lošom tolerancijom od strane pacijenata.
Gonoreja otporna na antibiotike
Gonokok ima svojstvo preuzimanja raspadnutog genetskog materijala drugih bakterija, što može rezultirati razvojem rezistencije.
Neisseria gonorrhoeae ili gonokok uzročnik je gonoreje ili kapavca, polno-prenosive bolesti koja zahvata sluznicu mokraćne cevi, vrata maternice, rektuma, ždrela i oka. Kvasac gonoreja može dovesti do karlične upalne bolesti, vanmaternične trudnoće, neplodnosti i povišenog rizika za zarazu virusom humane imunodeficijencije. Takođe se može preneti sa majke na dete i izazvati slepilo ili po život opasne infekcije novorođenčeta. Radi se o zaraznoj bolesti koja je rasprostranjena u čitavom svetu, stoga je i rastuća rezistencija ove bakterije postala globalni problem.
Bakterija ima svojstvo preuzimanja raspadnutog genetskog materijala drugih bakterija, što menja njen genetički profil i u određenim slučajevima rezultira rezistencijom. Tim su procesom poznatim kao transformacija različiti sojevi gonokoka postali rezistentni na sve klase antimikrobnih lekova osim jedne: cefalosporina. Ipak, noviji podaci pokazuju da čak i ovi lekovi polako gube svoju aktivnost protiv sojeva pronađenih širom sveta. Jedan od takvih sojeva je i HO41 otkriven u Japanu. Zbog toga danas empirijska terapija u lečenju gonoreje više ne prolazi; kod svake sumnje na ovu bolest uzročnika je potrebno dokazati u mikrobiološkom laboratoriju te napraviti test osetljivosti na antibiotike.
zaključak
Četiri su ključna koraka u borbi protiv „superbakterija“: sprečavanje infekcija poboljšanjem higijensko-sanitarnih mera, epidemiološko praćenje rezistentnih sojeva, racionalno korišćenje antibiotika te razvoj novih antibiotika i dijagnostičkih testova. Bakterije će nesumnjivo pronaći načine da se odupru i najnovijim antimikrobnim lekovima koji su tek u istraživanju, zbog čega su potrebne agresivne mere kako bi sprečili razvoj novih, ali i širenje već postojećih oblika rezistencije.
BioImunitet kapi na bazi biljke ehinacea i planinskog lekovitog bilja brzo podižu nivo belih krvnih zrnaca i imunitet, jačaju odbrambene sposobnosti tela i podstiču vitalnost. Posebno su dragocene kod hroničnih upala i infekcija. Koriste se samostalno ili uz lekove. Možete ih naručiti putem maila [email protected] ili telefonom 065 970 7777
Doc. Dr. Sc. Tomislav Meštrović, dr. Med.
Specijalista medicinske mikrobiologije sa parazitologijom